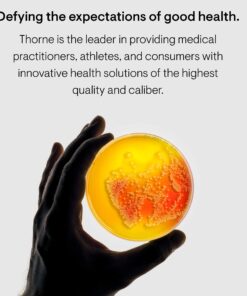
Thorne Vitamin K2 Liquid (1 mg per Drop) - Concentrated Vitamin K2 Supplement for Heart and Bone Support - 1 Fl Oz 15 816 Ez4jriL

Thorne Vitamin K2 Liquid (1 mg per Drop) – Concentrated Vitamin K2 Supplement for Heart and Bone Support – 1 Fl Oz
Description
Features:
- Helps maintain bone health
- Support a healthy heart and blood vessels
- 1 mg of Vitamin K2 (MK4) per drop
- Thorne products contain ingredients from the purest sources worldwide. Flavors, colors, preservatives, and sweeteners are derived from natural sources. Our products never contain gluten, Genetically Modified Organisms (known as GMOs), artificial preservatives, stearates, wheat, rye, barley, eggs, or nuts. This product does not contain dairy, soy, corn, sugar, or magnesium stearate
- Thorne's commitment to integrity and science-backed products has helped us earn the trust of thousands of health-care professionals, U.S. National Teams, the Mayo Clinic, and families around the world
Product Details:
- Brand: Thorne
- Item Form: Liquid
- Primary Supplement Type: Magnesium
- Diet Type: Gluten Free
- Flavor: Unflavored
- Is Discontinued By Manufacturer : No
- Date First Available : April 11, 2005
- Manufacturer : Thorne Research

4-Pack - P5-D Culligan Compatible Sediment Water Filter Cartridge - Also Replaces, Aqua-Pure AP110 & AP110-NP, Whirlpool WHKF-GD05 and DuPont WFPFC5002 by CFS
Honda 72560-VH8-642AH Semi-Matic Trimmer Head